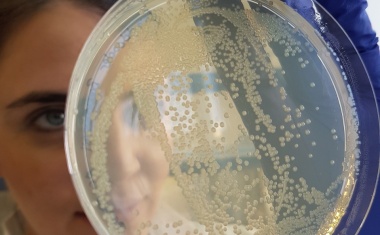
Photo

Weitere Verbreitung von Carbapenem-resistentem Acinetobacter baumannii muss vermieden werden
Forschende des Deutschen Zentrums für Infektionsforschung von der Universität zu Köln haben eine Studie zu dem Carbapenem-resistenten Bakterium Acinetobacter baumannii durchgeführt.